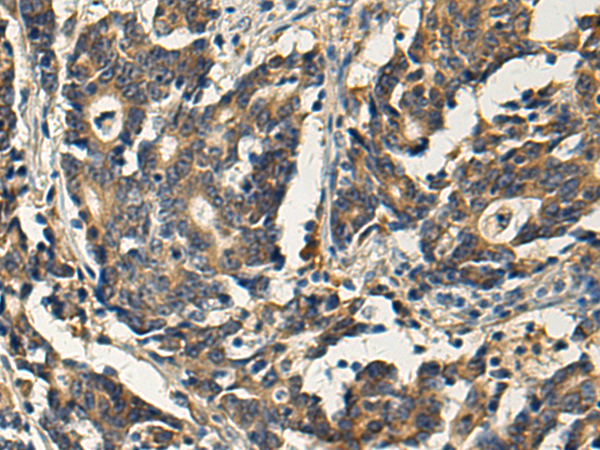
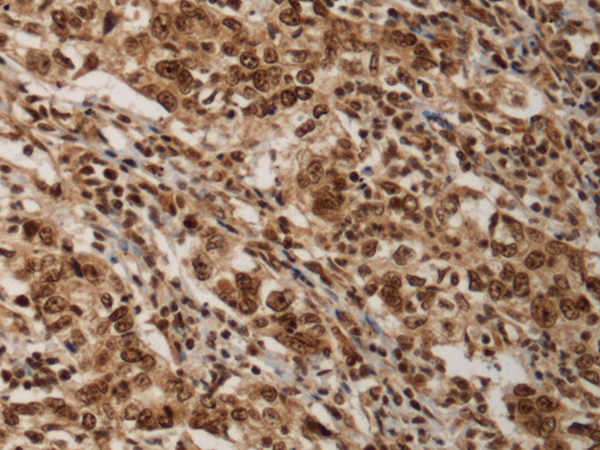

-
分类: 科研抗体货号: P10469别名: FXC1; Tim9b; TIM10B应用: IHC反应种属: Human, Mouse, Rat
-
分类: 科研抗体货号: P10468别名: RP84; DDX38; PRP16; PRPF16应用: IHC反应种属: Human
-
分类: 科研抗体货号: P10467别名: PE; HPS; HPS2; ADTB3; ADTB3A应用: IHC反应种属: Human, Mouse, Rat
-
分类: 科研抗体货号: P10486别名: FSG1; FRG1A应用: IHC反应种属: Human, Mouse
-
分类: 科研抗体货号: P10506别名: p2; p3; p4; RRP6; PMSCL; Rrp6p; PM-Scl; PMSCL2; PM/Scl-100应用: WB,IHC反应种属: Human
-
分类: 科研抗体货号: P10466别名: BRAG2; GEP100; ARFGEP100; ARF-GEP100应用: IHC反应种属: Human, Mouse
-
分类: 科研抗体货号: P10485别名: C3orf68应用: WB,IHC反应种属: Human, Mouse
-
分类: 科研抗体货号: P10505别名: RLP1; GOSPEL应用: WB,IHC反应种属: Human, Mouse, Rat
-
分类: 科研抗体货号: P10465别名: HK1应用: IHC反应种属: Human, Mouse
-
分类: 科研抗体货号: P10484别名: DPH4; JJJ3; ZCSL3应用: IHC反应种属: Human, Mouse

鄂公网安备42018502007531号
鄂公网安备42018502007531号

